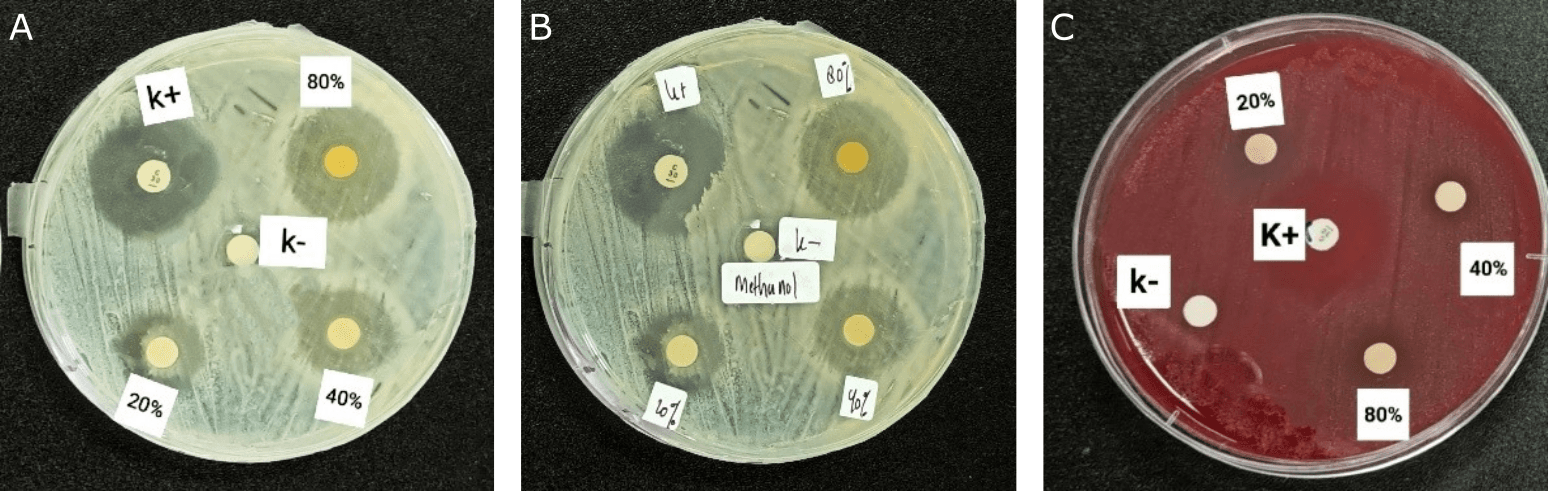
Figure 1. Antibacterial activity of the methanol extract of kecombrang stems against (A) Staphylococcus aureus, (B) Staphylococcus epidermidis, and (C) Propionibacterium acnes.

RESEARCH ARTICLE
Antibacterial Activity of Kecombrang (Etlingera elatior) Stems Against Skin Infection-Causing Bacteria
Sciences of Pharmacy|Vol. 4, Issue 3, pp. 127-132 (2025)
Received
Mar 28, 2025Revised
Jun 4, 2025Accepted
Jul 1, 2025Published
Jul 21, 2025
Abstract
Keywords:
Introduction
Skin diseases are among the most common health problems encountered, significantly impacting patients' quality of life. Among the various skin diseases, bacterial skin infections are among the leading causes (1). Skin infections occur due to an imbalance between the pathogenic microorganisms' ability and the human body's defense mechanisms (2). Various bacteria that cause skin infections include S. aureus, S. epidermidis, and P. acnes (3). These bacteria can cause multiple diseases, including folliculitis, impetigo, cellulitis, abscesses, ecthyma, and acne (4-6). Skin diseases, including skin infections, rank third, accounting for around 4.6-12.9% of Indonesia's 10 most common diseases (7). This high prevalence is primarily influenced by the tropical climate, which supports the growth of microorganisms, including bacteria (8). Skin infections caused by bacteria can be treated with antibiotics. However, the irrational use of antibiotics can lead to resistance (9). The application of traditional medicine in healthcare services globally is increasing, particularly in the treatment of infections and the prevention of drug resistance (10).
Kecombrang (Etlingera elatior) is one of the plants that can be used as an alternative to treat skin infections. Ethnopharmacologically, kecombrang stems are used by the Batak and Gayo people as an antiseptic (11). In addition, in Baduy, kecombrang stems are used as a substitute for soap to clean the skin (12). Kecombrang stems contain alkaloids, tannins, saponins, and flavonoids (13). The compound analysis results show that the kecombrang stem methanol extract contains biondinin A, methyl kushenol C, punicic acid, and malvalic acid (14). Kecombrang stem extract exhibits antibacterial activity against Bacillus subtilis, Escherichia coli, Pseudomonas aeruginosa, Salmonella enterica, and Streptococcus mutans (15, 16).
Several studies have reported that kecomberang stems contain secondary metabolites and exhibit antibacterial activity; however, the effectiveness of these compounds against bacteria that cause skin infections, such as S. aureus, S. epidermidis, and P. acnes, as well as the active compounds from kecombrang stems that act as antibacterials, remains unknown. Therefore, antibacterial activity testing is necessary, which includes effectiveness testing using the disc diffusion method, minimum inhibitory concentration (MIC) analysis, and TLC-bioautography analysis to identify the group of compounds that contribute to the antibacterial activity.
Experimental Section
Materials
The samples used in this research were Etlingera elatior (Jack) R. M. Sm stems, also known as batang kecombrang, collected from Pandeglang, Banten. The plant has been identified and authenticated at the Biology Laboratory, Faculty of Science and Technology, Ahmad Dahlan University, Yogyakarta, with letter number 163/Lab. Bio/B/III/2024, S. aureus strain ATCC 25923, S. epidermidis strain ATCC 12228, and P. acnes strain ATCC 11827, methanol technical grade (PT. Pentana Multi Karya, Indonesia), paper discchloramphenicol 30µg (Oxoid Ltd, United Kingdom), chloroform pro analysis grade (CAS 67-66-3, Merck, Germany), distilled water (Brataco, Indonesia), ammonia vapor pro analysis grade (CAS 7664-41-7, Merck, Germany), Nutrient Agar (NA) (Merck, Germany), Nutrient Broth (NB) (Merck, Germany), Trypticase Soy Broth (TSB) (Merck, Germany), Blood Agar Media (Himedia Laboratories, India), DMSO 5% technical grade (CAS 67-68-5, Merck, Germany), Silca gel F254 (Merck, Germany), and ELISA reader (Multiskan FC, Thermo Fisher Scientific, USA).
Kecombrang Stems Extraction
Extraction was carried out using the kinetic maceration method. 400 g of kecombrang simplicia was extracted using a methanol solvent at a 1:20 ratio for 2 h (14).
Analysis of Residual Solvent
An amount of 2 g of extract was dissolved in 25 mL of water and placed into a distillation flask at a temperature of 78.5 °C. The distillation was recorded until the volume of the distillate was approximately 2 mL less than that of the test liquid. Distillation was carried out for 2 h or until no more liquid dripped from the condenser. Subsequently, 25 mL of water was added, and the specific gravity of the liquid was measured at 25 °C. The specific gravity was then used to calculate the remaining solvent obtained (17).
Antibacterial Assay
The bacterial cultures used in this study were S. aureus ATCC 25923, S. epidermidis ATCC 12228, and P. acnes ATCC 11827. Antibacterial testing was carried out using the disc diffusion method (Kirby-Bauer Test). S. aureus and S. epidermidis bacteria were suspended in Nutrient Agar (NA), and P. acnes bacteria were suspended in Trypticase Soy Broth (TSB) until turbidity was obtained that corresponded to the McFarland standard. Farland 0.5 standard turbidity to get a bacterial count of 1-2 x 108 CFU/mL (18). Tests were carried out at concentrations of methanol extract from kecombrang stems of 80%, 40%, and 20%, a negative control (DMSO 5%), and a positive control (30 µg chloramphenicol paper disc). 10 µL of each test sample was dropped onto a paper disc (diameter 6 mm). Next, the discs are placed on the surface of the solidified agar media. Incubation is carried out for 18-24 h at a temperature of 37 °C (19).
Determination of Microbial Inhibitory Concentration (MIC)
MIC was determined by the microdilution method using a 96-well microtiter plate. Each test solution was prepared at concentrations of 20.000 ppm, 10.000 ppm, 5.000 ppm, 2.500 ppm, 1.250 ppm, 625 ppm, 312.5 ppm, and 781.25 ppm. Put into the well 50 µL of NB media (S. aureus and S. epidermidis) and TSB media (P. acnes) as well as 50 µL of the test bacterial suspension, which has been adjusted to the 0.5 McFarland standard. 100 µL of bacterial suspension, chloramphenicol solution, media control, and solvent control were included as controls for the test bacteria. Cell density was measured before incubation using an ELISA reader. After 24 h of incubation, cell density was measured again using an ELISA reader with a wavelength of 595 nm (20). The %inhibition of bacterial growth (MIC) is calculated using Eq. 1 (21).
Evaluation of Antibacterial Compound
Evaluation of antibacterial compounds using TLC Bioautography. TLC Bioautography testing utilized a mobile phase of chloroform: methanol (2:8) and a stationary phase of Silica gel F254. (2:8) and a stationary phase of Silica gel F254. After elution, nutmeg spots appeared on the TLC plate and were observed under visible light and UV light with wavelengths of 254 and 366 nm. Visible stains are marked. TLC Bioautography is carried out by placing a chromatogram plate on the surface of agar media that has been inoculated with the test bacteria, then storing it in the refrigerator for 60 min to allow the diffusion of antibacterial compounds from the chromatogram into the agar medium to be complete. The Petri dish was removed from the ice, and the TLC plate was removed from the agar surface. It was then incubated at 37 °C for 24 h (19). The formation of a clear zone around the agar medium indicates the presence of antibacterial activity. The TLC plate was evaporated with ammonia vapor to determine the type of compound that has antibacterial activity (22).
Statistical Analysis
The test results of antibacterial activity and %inhibition from the extract of the kecombrang stem were statistically processed using SPSS with a parametric one-way ANOVA.
Result and Discussion
Kecombrang Stems Extraction
The contracted extract was obtained from the kinetic maceration process, using a 1:10 ratio, specifically 400 g of kecombrang stem powder with 20 L of methanol solvent. The filtrate was concentrated using a rotary evaporator at 50 °C. The extracted material obtained was 18.3 g, corresponding to a yield of 4.57%.
Analysis of Residual Solvent
The solvent residue test is designed to verify that no solvent residue remains in the extract after the extraction process (23). The results of the study showed that the kecombrang stem extract did not contain methanol solvent residue. The level of solvent residue obtained qualifies the requirements, namely < 1%.
Antibacterial Activity
Antibacterial activity was determined using the disk diffusion method. The test results showed that the methanol extract of kecombrang stems exhibited antibacterial activity against S. aureus, S. epidermidis, and P. acnes, as indicated by the formation of a clear zone around the paper disc (see Figure 1). Tests were carried out with concentrations of 80%, 40%, and 20%, a negative control of DMSO at 0.5%, and a positive control of 30µg chloramphenicol disc paper. The use of a chloramphenicol positive control is based on the fact that chloramphenicol is a broad-spectrum antibiotic and is bactericidal. The mechanism of chloramphenicol antibacterial activity inhibits bacterial protein synthesis in the 50S ribosome subunit. It inhibits the peptidyl transferase enzyme, preventing the formation of peptide bonds during the protein synthesis process (24).

Based on the results (see Table 1), the methanol extract of the kecombrang stem has a more significant inhibition zone diameter on S. aureus and S. epidermidis than on P. acnes. These results can be attributed to the fact that the two bacteria belong to the same genus. In contrast to the results of antibacterial activity on P. acnes, the diameter of the inhibition zone produced is relatively small compared to the two previous types of bacteria. The antibacterial activity of the methanol extract of kecombrang stem against S. aureus at concentrations of 80%, 60%, and 20% yielded inhibition diameters of 25.53 ± 0.378 mm, 20.56 ± 0.321 mm, and 15.13 ± 0.251 mm, respectively. In contrast, the positive control, chloramphenicol, yielded 26.17 ± 0.351 mm, and the negative control, DMSO 0.5%, yielded 0 mm. The diameter of the inhibition zone produced on S. aureus bacteria is better compared to research by Sahidin et al. (15), which, at a concentration of 100 µg/mL, produces an inhibition zone diameter of 1.00 ± 0.20 mm. That is because the concentration used in the previous study was relatively small. That is because the concentration used is more significant than before. After all, the extract's concentration is one factor that affects the activity of an antibacterial substance (25). The results of data analysis using One-way ANOVA showed that differences in the concentration of kecombrang stem extract can significantly affect antibacterial activity against S. aureus, with a p-value of 0.000 (< 0.05).
| Substances | Concentrations | Inhibition zone (mm) | ||
|---|---|---|---|---|
| S. aureus | S. epidemidis | P. acnes | ||
| Methanol extract of kecombrang stems | 80% | 25.53 ± 0.378 | 24.73 ± 0.152 | 13.63 ± 0.208 |
| 40% | 20.56 ± 0.321 | 19.33 ± 0.152 | 10.57 ± 0.251 | |
| 20% | 15.13 ± 0.251 | 16.57 ± 0.251 | 9.23 ± 0.472 | |
| Positive control (30 µg chloramphenicol) | 26.17 ± 0.351 | 22.47 ± 0.152 | 35.37 ± 0.513 | |
| Negative control (DMSO 5%) | - | - | - | |
The antibacterial activity of the methanol extract of kecombrang stems The antibacterial activity of the methanol extract of kecombrang stems against S. epidermidis at concentrations of 80%, 60%, and 20% gave inhibition diameters of 24.73 ± 0.152 mm, 19.33 ± 0.152 mm, and 16.57 ± 0.251 mm, the positive control, chloramphenicol 22.47 ± 0.152 mm, with p-value 0.000 (< 0.05), showed that differences in the concentration of kecombrang stem extract can significantly affect antibacterial activity.
Antibacterial activity of methanol extract of kecombrang stem against P. acnes at concentrations of 80%, 60%, and 20% gave inhibition diameters of 13.63 ± 0.208 mm, 10.57 ± 0.251 mm, and 9.23 ± 0.472 mm, the positive control chloramphenicol 35.37 ± 0.513 mm with p value 0.000 (< 0.05), showed that differences in the concentration of kecombrang stem extract can significantly affect antibacterial activity.
The antibacterial activity of a substance can be influenced by the content of metabolite compounds in the extract, the concentration of the extract, the extract's diffusion rate, and the type of bacteria inhibited (25). The three types of test bacteria include gram-positive bacteria, which have more polar cell walls. As a result, bioactive compounds that are polar can quickly enter the cell wall and damage peptidoglycan, which is more polar than the lipid layer, which is non-polar and more difficult for non-polar antibacterial compounds to penetrate (26).
Minimum Inhibitory Concentration
The microdilution method is a development of the liquid dilution method, which uses media, bacteria, and test compounds in small quantities on a 96-well microplate (20). In this method, the resulting turbidity of the solution is observed using an ELISA reader as an optical density (OD) value to calculate the % inhibition (see Figure 2).

Based on the research results, the methanol extract of kecombrang stem at a concentration of 20.000 ppm can inhibit the growth of S. aureus by 98.25%, with the MIC value at a concentration of 78.125 ppm producing an inhibitory power of 33.74%. The statistical analysis showed a p value = 0.01 (< 0.05), indicating that the difference in concentration significantly affected the %inhibition of S. aureus. On S. epidermidis, the extract at a concentration of 20.000 ppm produced an inhibitory of 97.73%, with the MIC at a concentration of 78.125 ppm producing an inhibitory of 14.45%. The statistical test showed a p value = 0.00 (< 0.05), indicating that the concentration difference significantly affected the % inhibition of S. epidermidis. A concentration of 20.000 ppm on P. acnes showed an inhibitory power of 79.98%, with an MIC of 78.125 ppm; the inhibitory power was 3.5%. The p-value = 0.000 (< 0.05) indicates that the difference in concentration also significantly affects the %inhibition of P. acnes.
Determining Antibacterial Compound
Evaluation of antibacterial compounds using TLC Bioautography. TLC-Bioautography testing was conducted to determine the compound components in the extract responsible for antibacterial activity. The TLC-Bioautography method was chosen because it is simple to carry out, easy to observe, and requires relatively few samples (19). The results of the TLC mobile phase optimization for the methanol extract yielded chloroform: methanol (2:8) as the selected eluent, which produced two distinct stains (see Figure 3).

The results of the bioautography TLC test for the methanol extract showed a stain spot that provided a clear area on the agar media inoculated with bacteria, indicating that the spot inhibited the growth of the test bacteria. The antibacterial activity was declared positive if it produced a clear inhibitory zone on the agar media. Based on the test results (see Figure 4), stains that have antibacterial activity against S. aureus, S. epidermidis, and P. acnes bacteria are only found in stains with an Rf value of 0.42. The compounds were identified in TLC using ammonia vapor as the developing agent. The results of spraying each reagent on the TLC plate only changed the color of the ammonia vapor reagent with an Rf value of 0.42, specifically spots that did not exhibit a visible color but instead turned yellow. This occurs because flavonoids and ammonia react to form salts and a specific structure in ring B, which lengthens the conjugated double bonds, thereby increasing color intensity (27). Flavonoid chemicals function as antibacterials by disrupting the cytoplasmic membrane, inhibiting energy production, and preventing the synthesis of nucleic acids (28). These results align with previous research, which states that kecombrang stems contain flavonoid compounds, namely methyl kushenol C (14). This compound has been shown to have antibacterial properties against B. subtilis, S. aureus, Serratia marcescens, and E. coli (29).

Conclusion
Kecombrang stems show potential as a natural antibacterial agent. The methanol extract exhibited antibacterial activity against S. aureus, S. epidermidis, and P. acnes, with inhibition zone diameters ranging from 9.23 ± 0.472 mm to 25.53 ± 0.378 mm. The highest inhibition was observed against S. aureus. Minimum Inhibitory Concentration (MIC) results at 78.12 ppm showed growth inhibition of S. aureus by 33.74%, S. epidermidis by 14.45%, and P. acnes by 3.5%. TLC bioautography analysis confirmed that flavonoids are active antibacterial compounds. These findings support the potential use of kecombrang stems as a natural alternative for treating bacterial skin infections.
Abbreviations
MIC = Microbial Inhibitory Concentration; TLC = Thin Layer Chromatography; ELISA = Enzyme-Linked Immunosorbent Assay; ATCC = American Type Culture Collection; DMSO = Dimethyl Sulfoxide.
Declarations
Conflict of Interest
The authors declare no conflicting interest.
Data Availability
The unpublished data is available upon request to the corresponding author.
Funding Information
The author(s) declare that no financial support was received for the research, authorship, and/or publication of this article.
References
- Xue Y, Zhou J, Xu BN, Li Y, Bao W, Cheng XL, et al. Global Burden of Bacterial Skin Diseases: A Systematic Analysis Combined With Sociodemographic Index, 1990–2019. Front Med (Lausanne). 2022 Apr 25;9.
- Hidayati AN, Damayanti, Sari M, Alinda MD, Reza NR, Anggraeni S, et al. Infeksi Bakteri Di Kulit. Infeksi Bakteri Di Kulit. Surabaya: Airlangga University Press; 2019.
- Luthfiyana N, Bija S, Anwar E, Laksmitawati DR, Rosalinda GL. Characteristics and activity of chitosan from mud crab shells on acne bacteria: Staphylococcus aureus, S. epidermidis and Propionibacterium acnes. Biodiversitas. 2022;23(12):6645–6651.
- Amano E, Uchida K, Ishihara T, Otsu S, Machida A, Eishi Y. Propionibacterium acnes-associated chronic hypertrophic pachymeningitis followed by refractory otitis media: A case report. BMC Neurol. 2020;20(1):1–7.
- Becker K. Pathogenesis of Staphylococcus aureus [Internet]. Elsevier Inc. Elsevier Inc. 2018. 13–38 p.
- Rabionet A, Vivar KL, Mancl K, Bennett AE, Shenefelt P. Ecthyma associated with Moraxella and Staphylococcus epidermidis. JAAD Case Rep. 2016 Nov 1;2(6):473–475.
- Kemenkes RI. Profil Kesehatan Indonesia Tahun 2020. Jakarta; 2021.
- Santoso FL, Anwar AI, Tabri F, Amin S, Andriani A, Indrus. Indriati, et al. Profil Penyakit Kulit Penduduk Perkampungan Terapung Kepulauan Tihi-tihi dan Selangan, Bontang, Kalimantan Timur, Indonesia. Cermin Dunia Kedokteran. 2024;15(2):67-70.
- Kemenkes RI. Modul Penggunaan Obat Rasional. Jakarta: Direktorat Jendral Bina Kefarmasian dan Alat Kesehatan. Direktorat Jenderal Farmasi dan Alat Kesehatan. 2014.
- Ghosh J, Palit P, Maity S, Dwivedi V, Das J, Sinha C, et al. Traditional medicine in the management of microbial infections as antimicrobials: Pros and cons. Antibiotics - Therapeutic Spectrum and Limitations. 2023 Jan 1;391–434.
- Saudah, Zumaidar, Darusman, Fitmawati, Roslim DI, Ernilasari. Ethnobotanical knowledge of Etlingera elatior for medicinal and food uses among ethnic groups in Aceh Province, Indonesia. Biodiversitas. 2022;23(8):4361–4370.
- Agustina ZA, Suharmiyati Nf, Ipa M. Penggunaan Kecombrang (Etlingera elatior) sebagai Alternatif Pengganti Sabun dalam Perilaku Hidup Bersih dan Sehat Suku Baduy. Media Penelitian dan Pengembangan Kesehatan. 2017;26(4):235–242.
- Effendi KN, Fauziah N, Wicaksono R, Erminawati, Arsil P, Naufalin R. Analysis of bioactive components and phytochemical of powders stem and leaves of kecombrang (Etlingera elatior). In: IOP Conference Series: Earth and Environmental Science. IOP Publishing; 2019. p. 1–16.
- Adini S, Kumala S, Setyahadi S, Stiani SN, Yusransyah Y. Optimasi Rasio Volume Pelarutdan Waktu Ekstraksi Terhadap Rendemen Ektrak Batang Keombrang (Etlingera elatior) serta Profil Metabolit Sekunder Menggunakan LC-MS/MS. Medical Sains : Jurnal Ilmiah Kefarmasian. 2023;8(1):299–307.
- Sahidin I, Wahyuni, Malaka MH, Fristiohady A, Saleh A, Marianti A. Antibacterial and radical scavenger activities of extract and compounds of Wualae (Etlingera elatior) stems from Southeast Sulawesi. IOP Conf Ser Mater Sci Eng. 2019;546(6).
- Suryani N, Nurjanah D, Indriatmoko DD. Aktivitas Antibakteri Ekstrak Batang Kecombrang (Etlingera elatior (Jack) R.M.Sm.) Terhadap Bakteri Plak Gigi Streptococcus mutans. Jurnal Kartika Kimia. 2019;2(1):23–29.
- Cahyani NPSE, Susiarni J, Dewi KCS, Melyandari NLP, Putra KWA, Swastini DA. KARAKTERISTIK DAN SKRINING FITOKIMIA EKSTRAK ETANOL 70% BATANG KEPUH (Sterculia foetida L.). Jurnal Kimia (Journal of Chemistry). 2019;
- Emelda, Safitri EA, Fatmawati A. Aktivitas Inhibisi Ekstrak Etanolik Ulva lactuca terhadap Bakteri Staphylococcus aureus. Pharmaceutical Journal of Indonesia. 2021;7(1):43–48.
- Ismed F, Putri N, Putra DP. Kajian Fitokimia Fraksi Etil Asetat dari Lichen Stereocaulon massartianum Hue. dan Uji Aktivitas Antibakteri dengan Metode KLT-Bioautografi. Jurnal Sains Farmasi & Klinis. 2020;7(2):164-171.
- Rollando R. Uji Antimikroba Minyak Atsiri Masoyi (Massoia aromatica) Terhadap Bakteri Streptococcus mutans. Majalah Farmasi dan Farmakologi. 2019;23(2):52–57.
- Pratiwi SUT, Lagendijk EL, Hertiani T, De Weert S, Cornellius AM, Van Den Hondel JJ. Antimicrobial effects of indonesian medicinal plants extracts on planktonic and biofilm growth of pseudomonas Aeruginosa and Staphylococcus Aureus. Int J Pharm Pharm Sci. 2015;7(4):183–191.
- Nurhasanah N, Gultom ES. Uji Aktivitas Antibakteri Ekstrak Metanol Daun Kirinyuh (Chromolaena odorata) Terhadap Bakteri MDR (Multi Drug Resistant) Dengan Metode KLT. JURNAL BIOSAINS. 2020;6(2):45–52.
- Depkes RI. Parameter Standar Umum Ekstrak Tumbuhan Obat. Departemen Kesehatan RI; 2000.
- Setiabudy R. Antimikroba. In: Gunawan SG, editor. Farmakologi dan Terapi. 5th ed. Jakarta: Badan Penerbit Fakultas Kedokteran Universitas Indonesia.; 2007.
- Safitri EI, Fithria RF, Saputro EW, Wijaya DY. Uji Potensi Antijerawat Secara In Vitro dan Ex Vivo dari Ekstrak Etanol Herba Alfalfa ( Medicago sativa L .). Jurnal Ilmu Kefarmasian Indonesia. 2021;19(2):254–261.
- Rohde M. The Gram-Positive Bacterial Cell Wall. Microbiol Spectr. 2019 May 31;7(3).
- Ladeska V, Dingga M. Kajian Farmakognosi dan Penetapan Kadar Flavonoid Total Herba Nanas Kerang (Tradescantia spathacea Sw.). Jurnal Sains Farmasi & Klinis. 2019;6(3):254-264.
- Tan Z, Deng J, Ye Q, Zhang Z. The Antibacterial Activity of Natural-derived Flavonoids. Curr Top Med Chem. 2022 Mar 7;22(12):1009–1019.
- Shah SR, Ukaegbu CI, Hamid HA, Alara OR. Evaluation of antioxidant and antibacterial activities of the stems of Flammulina velutipes and Hypsizygus tessellatus (white and brown var.) extracted with different solvents. Journal of Food Measurement and Characterization [Internet]. 2018;12(3):1947–1961.